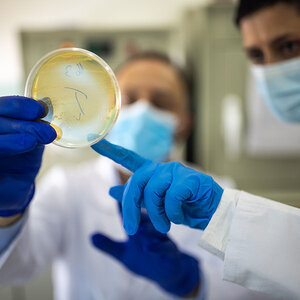

Novo Nordisk Foundation awards $25 million to CARB-X accelerator
The Denmark-based Novo Nordisk Foundation has awarded a three-year, $25 million grant to CARB-X (the Combating Antibiotic-Resistant Bacteria Biopharmaceutical Accelerator) to support early-stage development of products that treat, prevent, and diagnose antibiotic-resistant infections.
Established in 2016 at Boston University, CARB-X is a global nonprofit partnership funded by four G7 governments and three of the world’s biggest foundations. It provides support to developers of new vaccines, diagnostic tools, antibiotics, and other innovative interventions in the fight against antibiotic-resistant infections.
According to the Novo Nordisk Foundation, drug-resistant bacterial infections alone caused an estimated 3,500 deaths every day in 2019, a number on the rise and already higher than both HIV/AIDS and malaria. Since its creation, CARB-X has funded 93 projects in 12 countries. Nineteen projects have advanced into or completed clinical trials; 12 remain active in clinical development, including late-stage clinical trials; and two diagnostic products have reached the market.
“Like CARB-X, the Novo Nordisk Foundation is committed to driving innovation in the fight against drug-resistant infections,” said Novo Nordisk Foundation senior vice president of infectious diseases Peter Lawætz Andersen. “By partnering, we can help ensure that the best research gets translated into effective, scalable, and affordable medical interventions that can help end this growing pandemic.”
(Photo credit: Getty Images/miodrag ignjatovic)







